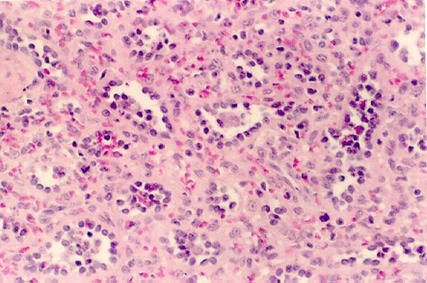
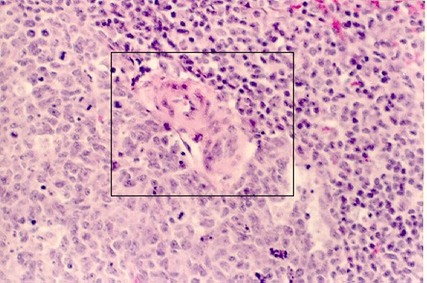

Lymph node
1) Hold up the lymph node slide to the light. Try to distinguish the cortex and the medulla. Lymph nodes are surrounded by a capsule and divided into an outer cortex and a central medulla. The cortex is distinguished by dense circular masses of lymphocytes called "nodules". In your slide of lymph node, find the capsule, cortex, medulla, sites of B cell production, sites of T cell storage.
The next photograph shows the connective tissue capsule and a region of the cortex. Find the subcapsular sinus. This is formed by the convergence of lymphatic vessels.

2) The photograph shows a lymph nodule with the dense region containing many B lymphocytes surrounding a germinal center.
The next field shows the continuation of the capsule into the lymph node as one of the trabeculae which is a connective tissue partition. What vessels run in the trabeculae?

The medulla of lymph nodes contains macrophages, more lymphocytes, and plasma cells. You identified them in the exercises on connective tissue. Below are sections of the lymph node medulla showing numerous cells sitting on sinuses. Find macrophages and plasma cells, once again in these fields. .The higher magnifications show these cell types.

Finally, as you study this material, be able to trace the blood supply as it penetrates the lymph node at the hilus and also the lymphatic supply as it penetrates the lymph node at the capsule. Why is the organization and direction of the lymphatic supply to the lymph node so important?
Palatine Tonsil
Patches of lymphoid tissue are found throughout the body. You will see some when you study the GI tract (Peyer's patches). An important accumulation of lymphoid tissue is found in the tonsils. This is essentially lymphoid tissue that is embedded in the wall of the pharynx, palate, nasopharynx. The epithelium is typical of that region so one can identify the tonsil by its epithelium. Also, there are crypts formed by invaginations of the epithelium which trap debris, bacteria, etc. This provides access to foreign antigens that stimulate the immune response. The following figure shows a view of a Palatine Tonsil. In your slide 35, find a palatine tonsil, lymphoid nodules, epithelium, and crypts. Where are the B and T cells stored in the tonsil?
The thymus is divided partially into rectangular-shaped lobes. The outer most regions of each lobe is the cortex and the inner regions are the medulla. The thymus also has a capsule that divides the lobes with connective tissue septa. Find each of these structures on your slide 36. Which vessels penetrate the capsule? Compare the blood supply of the thymus with that of the lymph node.
The following photograph shows the thymus cortex and the medulla. Find a Hassall's corpuscle.

A part of a rectangular-shaped lobule is shown above with the densely cellular cortex and the less cellular medulla. The thymic medulla is also more loosely arranged with many blood vessels and scattered cells. Be careful you don't mistake the thymic medulla and cortex for a lymph nodule with a germinal center. The lower photos are a higher magnification view of the medulla to show a characteristic epthelial structure called the Hassell's corpuscle (shown in the box). Whereas its function is not known, it can help you identify the thymus.

Trace the blood supply from the septa into the cortex. What happens to it when it penetrates the medulla. A photograph of a vessel is shown in the next figure.
It shows a vessel passing from the septa to the medulla.


Slide 37 shows a view of the spleen stained with Hemotoxylin and Eosin. This organ also has a capsule which continues into the spleen parenchyma as trabeculae. The large vessels travel in the trabeculae after they penetrate the spleen at the hilus. The parenchyma of the spleen is organized into red pulp and white pulp. The white pulp is easy to spot because it is lymphoid tissue with nodules and germinal centers. The red pulp has lots of red blood cells and sinusoids.


In the above photographs, find the capsule, red pulp and the white pulp. Can you see a nodule with a germinal center? Compare its structure with that in the lymph nodes.
Higher magnifications of the red pulp are shown in the next photos. Identify the sinusoids. What is special about the cells that line them (shape, function, etc).

A higher magnification through the white pulp is shown in the next photograph. The area in the box is the "central artery". Find this in your slide Trace the vascular supply from the trabeculae to the red pulp.
Be able to trace the blood supply from the splenic artery to the red pulp.
A Reticular fiber stain is used to detect reticular fibers, and this is shown below. The following micrographs show the basic fiber skeleton of the spleen on which the parenchyma sit. You can see the basic architecture, however. Find red pulp, white pulp and sinusoids in this slide as well. Label it on the following photos.


URL Address: http://microanatomy.net/immune_system/lymphoid_system.htm
Gwen V. Childs, Ph.D., FAAA
Department of Neurobiology and Developmental Sciences
University of Arkansas for Medical Sciences
4301 W. Markham, Slot 510, Little Rock, AR 72205
For questions or concerns, send email to this address
